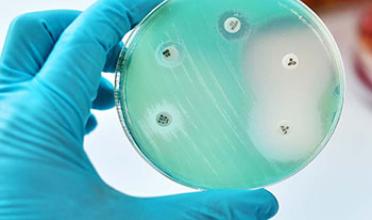
toevalsmedicijn

Preventie
Aantal Artikelen: 20
-
06 February 2018
Hoe een toevalsmedicijn ‘groot' werd
Antibioticaresistentie is levensgevaarlijk. Het is alweer 75 jaar geleden dat de Japanners een verrassingsaanval uitvoerden op de Amerikaanse...
-
25 January 2018
‘Ga met je vragen over seks naar de huisarts’
De huisarts kan antwoord geven op alle vragen rondom seksualiteit en advies geven over alle soorten anticonceptie. ’’Jongeren moeten daarnaast...